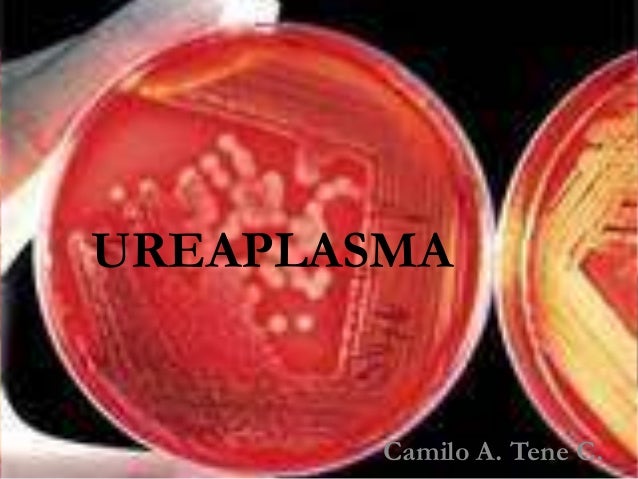

Урогенитальная микоплазма: фотографии бактерии под микроскопом
























)
















/data/photo/2019/12/04/5de771f6c0392.jpg)

Раздел: Другие животные